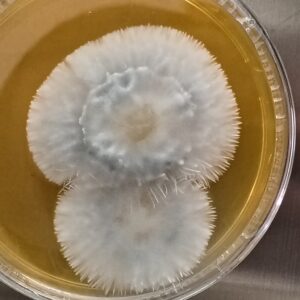
Winter Teacher (Psilocybe caeruleorhiza) Research Plate
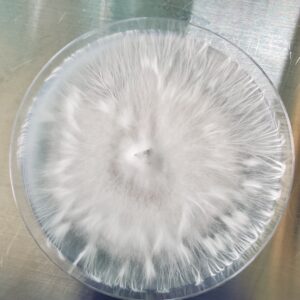
Pan. Cambo. "Komodo" x Pan, Cyan, "BVI" Research Plate 100mm

exotics
Showing all 12 resultsSorted by latest
-
See more products by: Wildcrafted Remedies Mycology
-
See more products by: Marvelous Mikes Fungal Forge
-
See more products by: PsyTeam United
-
See more products by: PsyTeam United
-
See more products by: Marvelous Mikes Fungal Forge
TTBVI (Tamarind Tree British Virgin Islands) Research Plate
Original price was: $30.00.$25.00Current price is: $25.00. -
See more products by: Marvelous Mikes Fungal Forge
-
See more products by: PsyTeam United
-
See more products by: Mr. Mycelium
-
See more products by: Marvelous Mikes Fungal Forge
-
See more products by: Marvelous Mikes Fungal Forge
-
See more products by: The Fungus Frequency
Psilocybe Ingeli Research Plate
Original price was: $35.00.$30.00Current price is: $30.00. -
See more products by: The Fungus Frequency
Psilocybe Ingeli Research Syringe
Original price was: $35.00.$30.00Current price is: $30.00.